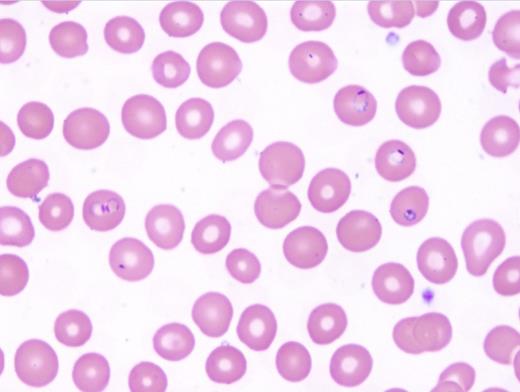
graphic
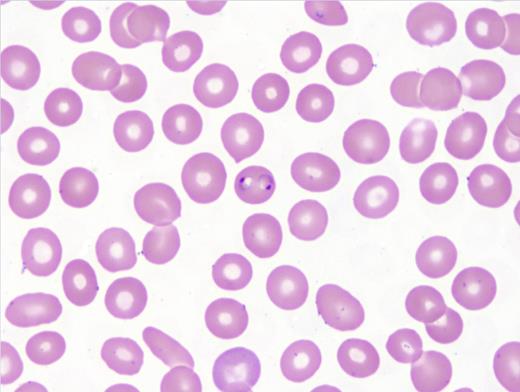
graphic

A 39-year-old man from Nigeria presented to an American emergency department with two days of chills, fevers, fatigue, vomiting, and headaches. He has a history of end-stage renal disease and was post–kidney transplantation two months prior in Nigeria. Representative images shown are Wright-Giemsa–stained thin (Figures 1 and 2) and thick (Figure 3) smears and a rapid antigen test (BinaxNow® Malaria test; Figure 4).
| Test . | Result . | Reference Range . |
|---|---|---|
| White blood cell count | 1.2 × 103/μL | 3.9-11 × 103/μL |
| Hemoglobin | 10.6 g/dL | 13.7-17 g/dL |
| Platelet count | 97 × 103/μL | 150-373 × 103/μL |
| Absolute neutrophil count | 0.71 × 103/μL | 1.9-7.8 × 103/μL |
| Test . | Result . | Reference Range . |
|---|---|---|
| White blood cell count | 1.2 × 103/μL | 3.9-11 × 103/μL |
| Hemoglobin | 10.6 g/dL | 13.7-17 g/dL |
| Platelet count | 97 × 103/μL | 150-373 × 103/μL |
| Absolute neutrophil count | 0.71 × 103/μL | 1.9-7.8 × 103/μL |
A. Malaria, Plasmodium falciparum infection
B. Malaria, Plasmodium vivax infection
C. Malaria, Plasmodium ovale infection
D. Malaria, Plasmodium malariae infection
Sorry, that was not the preferred response.
Correct!
Malaria is caused by parasites of the genus Plasmodium and is transmitted by the bite of an Anopheles mosquito, but occasionally, by blood transfusion, solid organ transplantation (SOT), needle sharing, or from mother to fetus. Post-transplantation malaria has been rarely reported in the literature, with most cases reported with kidney transplant. In such infections, parasites may be due to a donor-derived infection (DDI), reactivation of previous infection in the recipient, or de novo post-transplantation infection. DDI has been reported through transfusion of blood and blood products, through red blood cells (RBCs) within the transplanted organ, and through transplanted liver from infected donors.
Blood smear microscopy remains the most important diagnostic tool. Figures 1 and 2 reveal several infected RBCs with ring form trophozoites of P. falciparum, which are small and delicate, including some with the characteristic double chromatin dots, referred to as “headphone” or “Mickey Mouse ears.” Note some RBCs are infected with multiple ring forms and the parasitemia load is high — features common in P. falciparum infection. Additional features supporting a P. falciparum diagnosis are the non-enlarged size of the infected RBC and lack of Schűffner dots. The thick films (Figure 3) demonstrate frequent ring forms.
The rapid antigen test (BinaxNow® Malaria test) revealed a pattern positive for P. falciparum (Figure 4). Polymerase chain reaction tests detected Plasmodium falciparum DNA. The patient was treated with artemether and lumefantrine and his parasitemia resolved three days following admission.
Erythrocytes infected by P. vivax (Choice B) or P. ovale (Choice C) parasites often appear enlarged compared with adjacent, uninfected cells, whereas P. malariae and P. falciparum parasites are usually found in normal-sized RBCs. Schűffner’s stippling, noted as numerous small uniform pink granules in the RBC, is usually seen in RBCs infected with P. vivax and P. ovale and not P. malariae and P. falciparum infection. Young rings of P. falciparum are smaller than those of other species. Later-stage ring forms of P. falciparum are similar in size to those of the other species. Mature trophozoites and schizonts of P. falciparum are not seen in the peripheral blood except in severe cases of infection. Gametocytes of P. falciparum are identified by its characteristic banana shape. Gametocytes of the other species have a similar shape and thus are difficult to differentiate.
References
References
Dr. Arispe and Dr. Harrington indicated no relevant conflicts of interest.